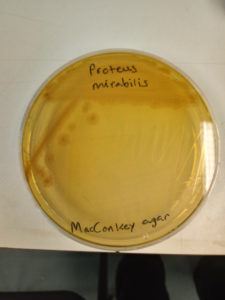
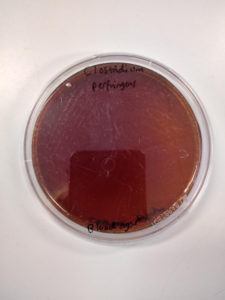
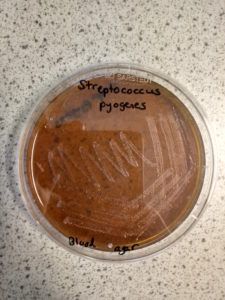
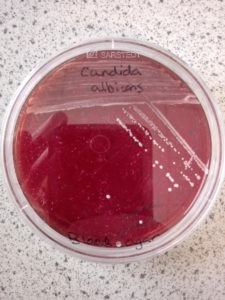
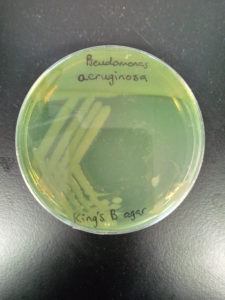
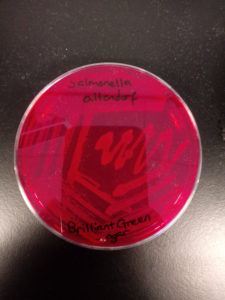
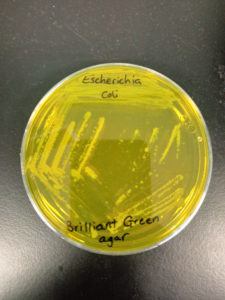
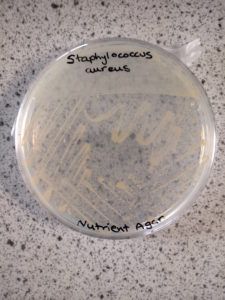

Profile
Jordan Kirby
WHOA those second round of eliminations were nervewracking! Ive survived for another day! Thanks for everybody who voted and keep those questions coming! :)
My CV
-
Education:
Aberystwyth University
-
Qualifications:
Bsc (Hons) Microbiology
-
Work History:
Royal Berkshire Hospital: Microbiology
-
Current Job:
Teaching and Research Technician
-
About Me:
Just a guy who loves Microbiology and Molecular genetics!
-
Read more
Hi all! My name is Jordan
I currently live in Hampshire but i grew up and lived in Reading for most of my life.
I have always loved science and from a young age i couldn’t dream of doing anything else! it wasnt untill the end of my A-levels that i truely knew which of the three sciences i wanted to actively pursue but i know i definetly made the right choice (GO Team Biology!)
The vast majority of my teen years was spent playing video games, Magic the Gathering and pen and paper roleplaying games.
I graduated in 2014 with a degree in microbiology from Aberystwyth University and since then i have worked in the field of microbiology (8 years in total if you also count my degree!).
I have previously worked in the clinical microbiology lab at the Royal Berkshire hospital where i played a key role identifying diseases and testing for antibiotic treatments (I’ve seen it all trust me!).My favorite meal is Beans on Toast (anticlimatic i know).
I am a massive fan of the Horror genre and I am always looking for new ways to scare myself, my favorite writers being Stephen King (This was probably going to be obvious), Junji Ito (A really really fantastic horror manga writer!) and H.P. Lovecraft (for those classical weird tales and cosmological horror).
I have very little spare time as i try and fill it up with things to do. My usual activities are:
– Playing bass guitar (sometimes even with other bandmates)– Reading Microbiology papers and journals (My usual commute is 2 hours each way so plenty of time to learn!)
– Playing video games (PC)
– Self teaching myself C++ (sadly programming wasn’t part of my school curriculum growing up D: )
– Running a weekly RPG game for my University friends
– Drawing from time to time
– Writing creative internet fictional horror for the SCP foundation
– Kitbashing and building things for Inq28
Hopefully this will give you a small insight to my character and if not feel free to ask!
-
Read more
My work has me doing lots of different things throught the year, during term time i am responsible for preparing a large variety of different bacteria and viruses for use with university classes, this often involves me modifying the bacteria’s DNA to make it behave differently to how it ususally would or knocking out gene functions alltogether!

Where the magic happens
I also oversee several research labs making sure Phd students people work safely, teach new starters and support third year project students during their final year dissertations (a project you have to do at the end of your degree).
During the summer time when there is no teaching I take on small lab based projects to expand my own knowledge aswell as assisting the labs. Previously i have worked on protein overexpression and purification of the protein EfeO (you will have to take my word it… it is very cool and interesting 🙂 )

Efe0 in all its glory!
(This was nearly a months work to get this working!) -
My Typical Day:
Coffee Fueled Microbiology
-
Read more
My typical day varies heavily depending on the time of the year. Although it will typically start with me grabbing a coffee and looking what lab work needs doing.
Currently i am doing transductions using bacteriophage (introducing DNA into a bacteria via the use of a virus known as a bacteriophage), so the first thing i will do on a regular morning will be checking to see if yesterdays batch of bacteria had successfully grown (if they have it means the viral DNA has been correctly inserted to my bacterial DNA!) and planning the day around that.

On somedays it even works! 😀
My other daily duties include:
- Attending lab meeting with Phd Students and academics
- Supporting 3rd year project students during thier lab based dissertations
- Demonstrating in practical classes
- Testing and trialing experements for academics
Like i said my days can vary quite a bit (no two days are ever truely the same!)
Below is a gallery of bacteria which i plated out to show what sort of variety of organisms i work with:
Proteus mirabilis
(Common cause of urinary tract infections)
Clostridium perfringens
(Causes over 90% of all gas gangrene cases)
Streptococcus pyogenes
(cause of strep pharyngitis and necrotizing fasciitis)
Candidia albicans
(Cause of the disease thrush)
Pseudomonas aeruginosa
(Causes the inner ear disease “Swimmers ear”)
Salmonella altendorf
(Part of the Salmonella genus, responsible for food poisoning)
Escherichia coli
(The true workhorse of microbiology! Can also cause disease depending on its location)
Staphlococcus aureus
(Causes staph skin infections and life threatening blood infections) -
What I'd do with the prize money:
Microbiology for Schools
-
My Interview
-
How would you describe yourself in 3 words?
Innovative, Fun and Knowledgeable
What did you want to be after you left school?
After finishing my A-Levels i definetly knew i wanted to pursue a career in microbiology. Nothing has changed since then!
Were you ever in trouble at school?
I wouldnt say i was trouble, but i did talk alot and joke about.
Who is your favourite singer or band?
It changes all the time! Currently its Tool
What's your favourite food?
Anything spicy!
If you had 3 wishes for yourself what would they be? - be honest!
The Ability to stop time, Immortality and My own fully funded microbiology research building.
Tell us a joke.
Scientists got bored watching the earth turn, so after 24 hours... They called it a day
-
